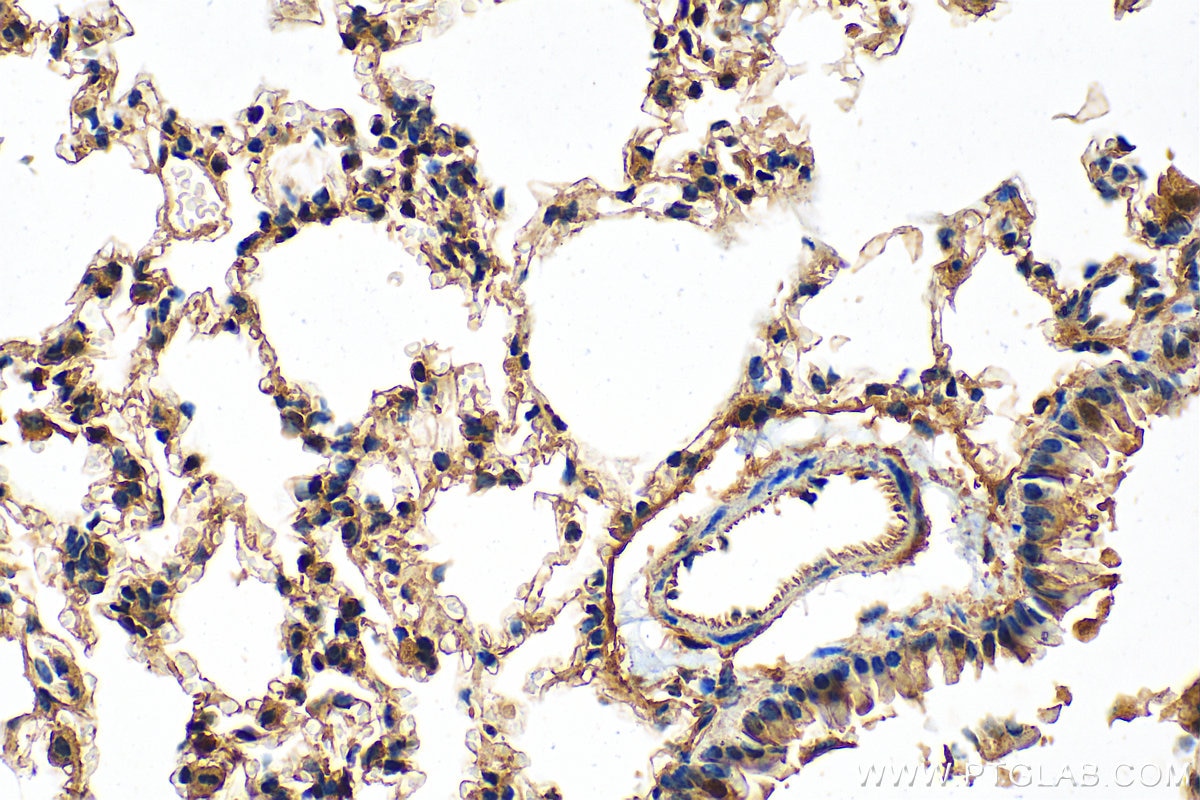
Immunohistochemical analysis of paraffin-embedded mouse lung tissue slide using 26564-1-AP (ABCA1 antibody) at dilution of 1:200 (under 40x lens). Heat mediated antigen retrieval with Tris-EDTA buffer (pH 9.0). Immunohistochemistry (IHC) staining of mouse lung tissue using ABCA1 Polyclonal antibody (26564-1-AP)

Tested Applications
| Positive WB detected in | mouse brain tissue, mouse cerebellum tissue |
| Positive IHC detected in | rat lung tissue, mouse lung tissue, rat liver tissue, rat stomach tissue Note: suggested antigen retrieval with TE buffer pH 9.0; (*) Alternatively, antigen retrieval may be performed with citrate buffer pH 6.0 |
Recommended dilution
| Application | Dilution |
|---|---|
| Western Blot (WB) | WB : 1:500-1:1000 |
| Immunohistochemistry (IHC) | IHC : 1:500-1:2000 |
| It is recommended that this reagent should be titrated in each testing system to obtain optimal results. | |
| Sample-dependent, Check data in validation data gallery. | |
Published Applications
| KD/KO | See 1 publications below |
| WB | See 20 publications below |
| IHC | See 3 publications below |
| IF | See 6 publications below |
Product Information
26564-1-AP targets ABCA1 in WB, IHC, IF, ELISA applications and shows reactivity with human, mouse, rat samples.
| Tested Reactivity | human, mouse, rat |
| Cited Reactivity | human, mouse |
| Host / Isotype | Rabbit / IgG |
| Class | Polyclonal |
| Type | Antibody |
| Immunogen |
CatNo: Ag24118 Product name: Recombinant human ABCA1 protein Source: e coli.-derived, PET28a Tag: 6*His Domain: 92-272 aa of BC141816 Sequence: GVVGNFNKSIVARLFSDARRLLLYSQKDTSMKDMRKVLRTLQQIKKSSSNLKLQDFLVDNETFSGFLYHNLSLPKSTVDKMLRADVILHKVFLQGYQLHLTSLCNGSKSEEMIQLGDQEVSELCGLPKEKLAAAERVLRSNMDILKPILRTLNSTSPFPSKELAEATKTLLHSLGTLAQEM Predict reactive species |
| Full Name | ATP-binding cassette, sub-family A (ABC1), member 1 |
| Calculated Molecular Weight | 2261 aa, 254 kDa |
| Observed Molecular Weight | 250 kDa |
| GenBank Accession Number | BC141816 |
| Gene Symbol | ABCA1 |
| Gene ID (NCBI) | 19 |
| RRID | AB_3085884 |
| Conjugate | Unconjugated |
| Form | Liquid |
| Purification Method | Antigen affinity purification |
| UNIPROT ID | O95477 |
| Storage Buffer | PBS with 0.02% sodium azide and 50% glycerol, pH 7.3. |
| Storage Conditions | Store at -20°C. Stable for one year after shipment. Aliquoting is unnecessary for -20oC storage. 20ul sizes contain 0.1% BSA. |
Background Information
The membrane-associated protein encoded by this gene is a member of the superfamily of ATP-binding cassette (ABC) transporters. ABC proteins transport various molecules across extra- and intracellular membranes. ABC genes are divided into seven distinct subfamilies (ABCA, MDR/TAP, MRP, ALD, OABP, GCN20, White). This protein is a member of the ABCA subfamily. Members of the ABCA subfamily comprise the only major ABC subfamily found exclusively in multicellular eukaryotes. With cholesterol as its substrate, this protein functions as a cholesterol efflux pump in the cellular lipid removal pathway.
Protocols
| Product Specific Protocols | |
|---|---|
| IHC protocol for ABCA1 antibody 26564-1-AP | Download protocol |
| WB protocol for ABCA1 antibody 26564-1-AP | Download protocol |
| Standard Protocols | |
|---|---|
| Click here to view our Standard Protocols |
Publications
| Species | Application | Title |
|---|---|---|
Clin Transl Med Tumour-associated macrophage-derived DOCK7-enriched extracellular vesicles drive tumour metastasis in colorectal cancer via the RAC1/ABCA1 axis
| ||
Phytomedicine Rice bran active peptide (RBAP) inhibited macrophage differentiation to foam cell and atherosclerosis in mice via regulating cholesterol efflux | ||
Atherosclerosis Flagellar hook protein FlgE promotes macrophage activation and atherosclerosis by targeting ATP5B | ||
Redox Biol S-nitrosylation of HINT1 in macrophages aggravates foam cell formation and atherosclerosis. | ||
Pharm Biol lncRNA MALAT1-mediated regulation of cholesterol-oxidative stress-iron metabolic dysregulation by paeoniflorin in osteoarthritic chondrocytes. | ||
Int Immunopharmacol Inhibition of ferroptosis alleviates atherosclerosis and foam cell formation by regulating lipid metabolism via AMPK activation |